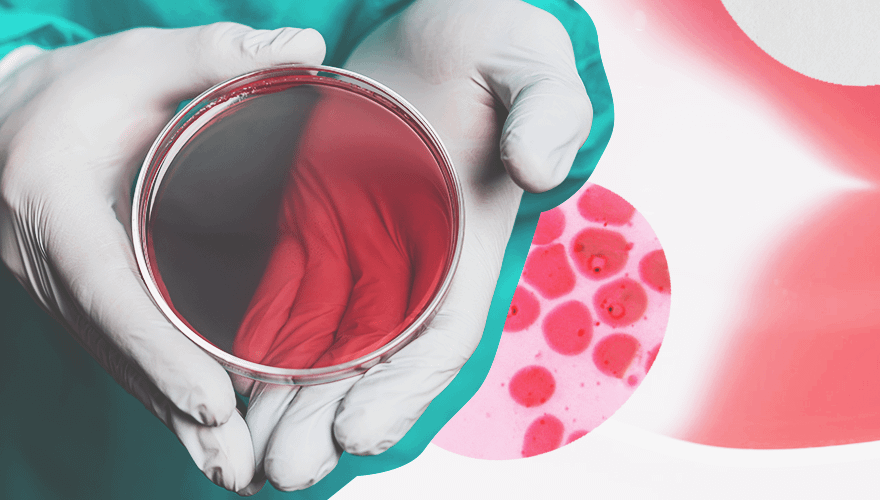

Сегодня женщины все чаще откладывают рождение первенцев на более поздний возраст: одни получают высшее образование и занимаются карьерой, другие путешествуют и занимаются саморазвитием. Между тем способность зачать, выносить и родить ребенка естественным образом в возрасте старше 35 лет начинает стремительно падать. Связана эта проблема с постепенным снижением количества и качества яйцеклеток. Вместе с греческим центром планирования семьи Crete Fertility Center рассказываем о современных технологиях в области репродуктивного здоровья, которые дают шанс на рождение ребенка даже пациенткам с ранней менопаузой.
1. PRP-терапия
PRP-метод вагинального омоложения — это комплексный подход терапевтического лечения расстройств, связанных с отсутствием желания близости, сексуальной дисфункцией, вагинальной сухостью, а также недержанием мочи. Процедура может сочетаться с омоложением матки и яичников в рамках целостного терапевтического подхода.
Процедура проходит следующим образом. Врач забирает кровь из вены и помещает в специальное оборудование, где кровь разделяется на тромбоциты, лимфоциты, эритроциты. Полученная плазма, богатая тромбоцитами, вводится в верхнюю часть внутренней стенки влагалища и клитора, стимулируя белки, а они в свою очередь регенерируют новые ткани. Стимуляторы роста, которые высвобождаются из активированных тромбоцитов плазмы, повышают местную выработку коллагена и эластина. Все это способствует утолщению стенок и улучшению увлажнения влагалища. Это абсолютно безопасно, поскольку на организм пациентки воздействуют не лекарства, а ее собственные ресурсы.
Кроме того, PRP-терапия исключает хирургическое вмешательство, проводится под легкой анестезией с помощью трансвагинального метода исследования и не требует долгого восстановительного периода.
Узнать подробнее о PRP-терапии
2. Иглоукалывание
Иглоукалывание в последние годы стало активно применяться в качестве основного или дополнительного средства для решения некоторых гинекологических проблем. Многие врачи назначают сеансы акупунктуры тем, кто лечится от дисменореи, синдрома поликистозных яичников, неприятных симптомов менопаузы или уже готовится к экстракорпоральному оплодотворению.
Для лечения бесплодия используются специальные терапевтические протоколы иглоукалывания, которые индивидуально подбираются врачом для каждой пациентки. Хотя многие относятся к процедуре скептически, — исследования показывают, что сеансы иглотерапии приводят эндокринную систему в норму и способствуют общему оздоровлению женского организма. Эффективность иглоукалывания в улучшении женского бесплодия основана в основном на его воздействии на нервную и эндокринную системы, регулировании и балансировании гормонов, а также снижении стресса.
Так, несколько сеансов иглотерапии призваны улучшить овуляцию и усилить приток крови к артериям матки, что увеличивает вероятность успешной имплантации оплодотворенной яйцеклетки. Кроме того, некоторые исследования утверждают, что процедура благоприятно влияет на подвижность сперматозоидов и качество спермы. Медицинская акупунктура считается безопасным методом без побочных эффектов, если ее проводит специально обученный врач.
Процедура иглоукалывания способна также увеличивать шансы на успешную беременность при ЭКО за счет:
- стимуляции овуляции и выработку более качественных яйцеклеток;
- улучшения кровоснабжения эндометрия и увеличения шансов успешной имплантации оплодотворенной яйцеклетки во время переноса эмбриона;
- снижения тонуса матки;
- уменьшения боли в процессе овуляции;
- уменьшения количества внематочных беременностей;
- снижения стресса, который пара может испытывать во время процедуры ЭКО.
Узнать подробнее об иглотерапии
3. Расширенный молекулярный анализ эндометрия
Исследования показывают, что примерно у 30% у женщин, страдающих бесплодием, обнаруживают эндометрит. В большинстве случаев болезнь обусловлена нарушением микробиома эндометрия, когда полезных лактобацилл становится меньше, а условно-патогенных бактерий, таких как кишечная палочка, клебсиелла и стрептококки, — больше.
В этом случае даже здоровый эмбрион, пройдя длинный путь по маточным трубам, не может прикрепиться к стенкам полости матки. Эндометрит бывает бессимптомным, но иногда сопровождается непривычными выделениями, болями в нижней части живота и при мочеиспускании, нерегулярностью цикла и повышением температуры тела.
Диагностировать проблему можно с помощью расширенного молекулярного анализа эндометрия. В ходе процедуры врач совершенно безболезненно забирает у пациентки образец эндометриальной ткани или жидкости с помощью специального инструмента. Затем проводит генетический анализ забранного материала, чтобы понять, какие именно бактерии спровоцировали болезнь. Это позволяет поставить верный диагноз и назначить лечение пробиотиками или антибиотиками для восстановления нормальной микрофлоры эндометрия.
Следует отметить, что расширенный эндометриальный анализ и пайпель-биопсия — это не одно и то же. Первый метод диагностики является одним из самых новых методов в данной области, он используется всего полтора года. Кроме того, эндометриальный анализ позволяет получить гораздо более подробную картину микробиома эндометрия, чем пайпель-биопсия.
Узнать больше о тестировании микробиома эндометрия
4. Процедура EmbryoGlue
EmbryoGlue (эмбриоклей) — это уникальная среда для переноса эмбрионов. Основной ее компонент — гиалуроновая кислота, которая естественным образом вырабатывается в матке. Высокая концентрация этого вещества позволяет EmbryoGlue лучше смешиваться с жидкостями в матке. Молекулы гиалуроновой кислоты, как мостики, связывают эмбрион и эндометрий, работая подобно клею и увеличивая вероятность прикрепления эмбриона к стенке матки.
EmbryoGlue применяется на этапе переноса эмбрионов при лечении методами вспомогательных репродуктивных технологий, увеличивая вероятность успешной имплантации эмбрионов для всех пациенток. Если тебе предстоит, например, пройти процедуру ЭКО, — ты можешь воспользоваться преимуществами препарата и помочь эмбрионам успешнее имплантироваться. Научные исследования выявили несколько категорий, для которых EmbryoGlue особенно эффективен:
- пациентки старше 35 лет;
- пациентки с эмбрионами низкого качества;
- пациентки с опытом нескольких неудачных процедур с использованием вспомогательных репродуктивных технологий;
- в циклах с заморозкой эмбрионов.
В дополнение к этому, рентабельная ценовая политика и высочайшие стандарты медицинской экспертизы, науки и здоровья делают Критский центр фертильности лучшим выбором с точки зрения затрат, эффективности и безопасности для всех потребностей АРТ.
Помимо PRP-терапии, в Crete Fertility Centre занимаются ЭКО, ведением беременности, кольпоскопией, лечением нарушений менструального цикла, маммографией, акупунктурой, а также оказывают психологическую поддержку.

Вопрос нравственной стороны, ведь смертный грех, использовать технологии вроде эко, потому что часть оплодотворенных эмбрионов умерщвляется, это есть убийство